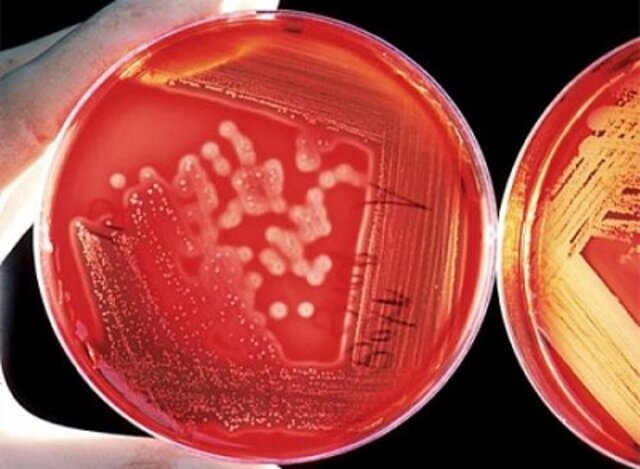
Método de enriquecimiento de cultivos

-
 Hooke descubrió las células observando en el microscopio una laminilla de corcho, dándose cuenta de que estaba formada por pequeñas cavidades poliédricas que recordaban a las celdillas de un panal. Por ello cada cavidad se llamó célula.
Hooke descubrió las células observando en el microscopio una laminilla de corcho, dándose cuenta de que estaba formada por pequeñas cavidades poliédricas que recordaban a las celdillas de un panal. Por ello cada cavidad se llamó célula. -
-
 Leeuwenhoek descubrió por primera vez lo que él llamaría "animálculos", y que en realidad hoy sabemos que son protozoos y bacterias. Fue el primero en ver los glóbulos rojos y los espermatozoides.
Leeuwenhoek descubrió por primera vez lo que él llamaría "animálculos", y que en realidad hoy sabemos que son protozoos y bacterias. Fue el primero en ver los glóbulos rojos y los espermatozoides. -
 El 14 de mayo de 1796 Edward Jenner vacuna al niño de ocho años James Phipps, quien posteriormente es expuesto a la viruela sin mostrar síntomas. Jenner demuestra la protección contra la viruela y diseña el método para extraer el material para la vacuna de las personas vacunadas.
El 14 de mayo de 1796 Edward Jenner vacuna al niño de ocho años James Phipps, quien posteriormente es expuesto a la viruela sin mostrar síntomas. Jenner demuestra la protección contra la viruela y diseña el método para extraer el material para la vacuna de las personas vacunadas. -
 Louis Pasteur estudió la fermentación y por qué esta descomponía y acidificaba el vino. Tras pocas semanas de estudio, Pasteur, descubrió que la sustancia que lo alteraba era el ácido láctico, producto de la fermentación láctica desencadenada por microorganismos.
Louis Pasteur estudió la fermentación y por qué esta descomponía y acidificaba el vino. Tras pocas semanas de estudio, Pasteur, descubrió que la sustancia que lo alteraba era el ácido láctico, producto de la fermentación láctica desencadenada por microorganismos. -
 Louis Pasteur realizó una serie de experimentos sumamente eficaces para demostrar definitivamente que también los microbios se originaban a partir de otros microorganismos.
Louis Pasteur realizó una serie de experimentos sumamente eficaces para demostrar definitivamente que también los microbios se originaban a partir de otros microorganismos. -
 Joseph Lister es uno de los pioneros del control de infecciones. No solo redujo la incidencia de infección de heridas (generalmente fatal antes de Lister) mediante la introducción de la cirugía antiséptica con ácido fénico, sino que también fue el primero en aplicar los principios de Pasteur a los humanos. Demostró que la orina podía mantenerse estéril después de hervirla en matraces.
Joseph Lister es uno de los pioneros del control de infecciones. No solo redujo la incidencia de infección de heridas (generalmente fatal antes de Lister) mediante la introducción de la cirugía antiséptica con ácido fénico, sino que también fue el primero en aplicar los principios de Pasteur a los humanos. Demostró que la orina podía mantenerse estéril después de hervirla en matraces. -
 Ferdinand Julius Cohn (1828-1898)
Ferdinand Julius Cohn (1828-1898)
Fundador de la microbiología moderna y es considerado el padre de la bacteriología. En 1872 propuso la clasificación de las bacterias gérmenes especies y variedades también descubrió otros microorganismos patógenos transmitidos por agua contaminada distinto al V. cholerae. -
 El trabajo de Robert Koch consistió en aislar el microorganismo causante de una enfermedad y hacerlo crecer en un cultivo puro. El cultivo puro fue utilizado para inducir la enfermedad en animales de laboratorio, en su caso la cobaya, aislando de nuevo el germen de los animales enfermos y comparándolo con el germen original.
El trabajo de Robert Koch consistió en aislar el microorganismo causante de una enfermedad y hacerlo crecer en un cultivo puro. El cultivo puro fue utilizado para inducir la enfermedad en animales de laboratorio, en su caso la cobaya, aislando de nuevo el germen de los animales enfermos y comparándolo con el germen original. -
 Robert Koch es recordado por el descubrimiento de la bacteria responsable de la tuberculosis (también llamada Bacilo de Koch), al igual que identificó la sustancia que actúa como remedio de la enfermedad, la denominada tuberculina.
Robert Koch es recordado por el descubrimiento de la bacteria responsable de la tuberculosis (también llamada Bacilo de Koch), al igual que identificó la sustancia que actúa como remedio de la enfermedad, la denominada tuberculina. -
 Metchnikoff observó que los polimorfos eran muy activos en la ingestión de bacterias y que los macrófagos lo eran de otras células. Concibió entonces la idea de que la atrofia senil del cuerpo humano podía deberse a una fagocitosis de los tejidos alterados.
Metchnikoff observó que los polimorfos eran muy activos en la ingestión de bacterias y que los macrófagos lo eran de otras células. Concibió entonces la idea de que la atrofia senil del cuerpo humano podía deberse a una fagocitosis de los tejidos alterados. -
En sus investigaciones sobre el carbunco bacteridiano, Koch descubrió que el patógeno se encontraba siempre en la sangre de los animales enfermos, por lo que, en una primera fase de investigación, tomó pequeñas muestras de sangre de estos animales y se las inoculó a animales sanos. El resultado fue la transmisión de la enfermedad y, por tanto, el establecimiento de la etiología de la enfermedad.
-
 La Tinción de Gram consiste en una técnica de laboratorio diseñada por Christian Gramen el año 1884. El objetivo de Gram era conseguir una prueba con la que fuera posible diferenciar diferentes grupos de bacterias para así poder estudiarlas y clasificarlas.
La Tinción de Gram consiste en una técnica de laboratorio diseñada por Christian Gramen el año 1884. El objetivo de Gram era conseguir una prueba con la que fuera posible diferenciar diferentes grupos de bacterias para así poder estudiarlas y clasificarlas.
Según la distribución del peptidoglicano de la pared celular que las envuelve, se tiñen de una forma u otra. -
 En 1885, el científico Louis Pasteur desarrolló la vacuna antirrábica. Su descubrimiento supuso uno de los mayores avances en la historia de la medicina.
En 1885, el científico Louis Pasteur desarrolló la vacuna antirrábica. Su descubrimiento supuso uno de los mayores avances en la historia de la medicina. -
 Los estudios de Sergei Winogradsky sobre la biología de los microorganismos reveló la significación metabólica de las transformaciones biogeoquímicas que llevaban a cabo. En este contexto, a lo largo de sus estudios sobre las bacterias oxidantes del azufre propuso el concepto de quimio litotrofía, es decir, la oxidación de compuestos inorgánicos acoplada a la obtención de energía utilizable.
Los estudios de Sergei Winogradsky sobre la biología de los microorganismos reveló la significación metabólica de las transformaciones biogeoquímicas que llevaban a cabo. En este contexto, a lo largo de sus estudios sobre las bacterias oxidantes del azufre propuso el concepto de quimio litotrofía, es decir, la oxidación de compuestos inorgánicos acoplada a la obtención de energía utilizable. -
 Martinus Beijerinck es considerado uno de los fundadores de la virología, y demostró, empleando filtros extremadamente finos, que el agente patógeno responsable de la enfermedad del mosaico del tabaco es mucho más pequeño que una bacteria. Él los nombra virus.
Martinus Beijerinck es considerado uno de los fundadores de la virología, y demostró, empleando filtros extremadamente finos, que el agente patógeno responsable de la enfermedad del mosaico del tabaco es mucho más pequeño que una bacteria. Él los nombra virus. -
 Shibasaburo Kitasato y Emil von Behring vacunaron conejillos de indias a base de una toxina de difteria con tratamiento térmico.
Shibasaburo Kitasato y Emil von Behring vacunaron conejillos de indias a base de una toxina de difteria con tratamiento térmico.
Kitasato y von Behring demostraron que los productos sanguíneos (o séricos) de los conejillos de indias contenían una sustancia que prevenía los efectos nocivos de la C. diphtheriae y su toxina cuando los conejillos eran expuestos nuevamente a dosis letales de la bacteria y la toxina. A esta sustancia le llamaron antitoxina. -
 Sergei Winogradsky. Con el descubrimiento de organismos que oxidan compuestos inorgánicos tales como sulfuro de hidrógeno y amonio como fuentes de energía, autótrofos podrían dividirse en dos grupos: fotoautótrofos y quimioautótrofos. Winogradsky fue uno de los primeros investigadores a intentar comprender microorganismos fuera del contexto médico..
Sergei Winogradsky. Con el descubrimiento de organismos que oxidan compuestos inorgánicos tales como sulfuro de hidrógeno y amonio como fuentes de energía, autótrofos podrían dividirse en dos grupos: fotoautótrofos y quimioautótrofos. Winogradsky fue uno de los primeros investigadores a intentar comprender microorganismos fuera del contexto médico.. -
Martinus Beijerinck inventó el medio de enriquecimiento, un método fundamental de estudio de los microorganismos del medio ambiente.
Martinus Beijerinck inventó el medio de enriquecimiento, un método fundamental de estudio de los microorganismos del medio ambiente. -
 Entre los años 1901 y 1903, Landsteiner se dio cuenta de que una reacción de rechazo ocurría cuando se intentaba recibir una transfusión de sangre de otros seres humanos y que precisamente esa era la causa de los shocks, ictericias y hemoglobinurias que se habían dado frecuentemente en intentos anteriores de transfusiones sanguíneas. En 1909, consiguió identificar los cuatro grandes grupos sanguíneos.
Entre los años 1901 y 1903, Landsteiner se dio cuenta de que una reacción de rechazo ocurría cuando se intentaba recibir una transfusión de sangre de otros seres humanos y que precisamente esa era la causa de los shocks, ictericias y hemoglobinurias que se habían dado frecuentemente en intentos anteriores de transfusiones sanguíneas. En 1909, consiguió identificar los cuatro grandes grupos sanguíneos. -
Paul Ehrlich
-
En 1911, Francis Rous consiguió aislar tal virus de un tumor canceroso de un pollo; infectó con él a otros pollos, que desarrollaron el mismo tumor. Ello supuso la primera prueba de que los virus son capaces de producir tumores cancerosos.
-
 Frederick Williams cultivó en medio líquido microorganismos contaminados, demostró que el filtrado contenía un componente que aparentemente tenía un efecto lítico, por lo que lo denominó "factor lítico bacteriano". Hizo algunos estudios al respecto, pero luego abandonó el asunto. En forma independiente, Félix Hubert d´Herelle informó sobre el hallazgo y la caracterización de un "microbio invisible antagónico del bacilo de la disentería", al cual denominó bacteriófago
Frederick Williams cultivó en medio líquido microorganismos contaminados, demostró que el filtrado contenía un componente que aparentemente tenía un efecto lítico, por lo que lo denominó "factor lítico bacteriano". Hizo algunos estudios al respecto, pero luego abandonó el asunto. En forma independiente, Félix Hubert d´Herelle informó sobre el hallazgo y la caracterización de un "microbio invisible antagónico del bacilo de la disentería", al cual denominó bacteriófago -
 En 1928, el microbiólogo Frederick Griffith, que investigaba varias cepas de neumococo (Streptococcus pneumoniae), inyectó en ratones la cepa S y la cepa R de la bacteria. Tras eliminar los lípidos, proteínas y polisacáridos, el estreptococo aún conservó su capacidad de replicar su ADN e introducirlo en neumococo R.
En 1928, el microbiólogo Frederick Griffith, que investigaba varias cepas de neumococo (Streptococcus pneumoniae), inyectó en ratones la cepa S y la cepa R de la bacteria. Tras eliminar los lípidos, proteínas y polisacáridos, el estreptococo aún conservó su capacidad de replicar su ADN e introducirlo en neumococo R. -
 Alexander Fleming descubrió la penicilina, al observar de forma casual sus efectos antibióticos sobre un cultivo bacteriano; fue obtenida a partir del hongo Penicillium notatum.
Alexander Fleming descubrió la penicilina, al observar de forma casual sus efectos antibióticos sobre un cultivo bacteriano; fue obtenida a partir del hongo Penicillium notatum. -
 El científico Cornelius van Niel postuló por primera vez en la década de 1930 que el oxígeno liberado de
El científico Cornelius van Niel postuló por primera vez en la década de 1930 que el oxígeno liberado de
la fotosíntesis proviene de la molécula de agua. A través de experimentos con bacterias, sugirió
por analogía, que el O2 liberado en la fotosíntesis de las plantas se deriva de H2O en lugar de CO2.
Antes de ese momento, se pensaba que el O2 provenía de la división de la molécula de CO2. -
Wendall Stanley
-
 George Beadle y Edward Tatum.
George Beadle y Edward Tatum.
Trabajando con cepas determinaron para cada mutante, la actividad enzimática que había quedado afectada, y la asociaron con la alteración de un gen. Concluyeron así que existía un gen para cada actividad enzimática. -
-
 Max Delbruck y Salvador Luria.
Max Delbruck y Salvador Luria.
El experillamado test de fluctuación, demuestra que en bacterias, las mutaciones genéticas se producen en ausencia de selección, en lugar de producirse como respuesta a la selección. Por lo tanto, la teoría de la selección natural de Darwin que actúa sobre mutaciones aleatorias puede también aplicarse sobre las bacterias y otros organismos más complejos. -
 El experimento de Avery-MacLeod-McCarty fue una demostración experimental, comunicada en 1944 por Oswald Avery, Colin MacLeod y Maclyn McCarty, de que el ADN es la sustancia que provoca la transformación bacteriana, en una época en la que se creía ampliamente que eran las proteínas las que cumplían la función de transportar la información genética.
El experimento de Avery-MacLeod-McCarty fue una demostración experimental, comunicada en 1944 por Oswald Avery, Colin MacLeod y Maclyn McCarty, de que el ADN es la sustancia que provoca la transformación bacteriana, en una época en la que se creía ampliamente que eran las proteínas las que cumplían la función de transportar la información genética. -
Selman Waksman y Albert Schatz
-
 Edward Tatum y Joshua Lederberg
Edward Tatum y Joshua Lederberg
En 1946, Lederberg y Tatum realizaron el experimento con Escherichia coli. Las dos cepas de E. coli A y B son incapaces de
crecer en medio mínimo. Tras cultivar juntas las dos cepas durante un tiempo corto y sembrar en medio mínimo las células procedentes de ese cultivo mixto, se observaron colonias prototrofas con una frecuencia muy baja. La aparición de estas células sólo puede explicarse por recombinación. -
 En la década de los ’20, Bárbara McClintock estudió el cambio de los cromosomas de cierta planta durante su reproducción, desarrollando una técnica para visualizarlos.
En la década de los ’20, Bárbara McClintock estudió el cambio de los cromosomas de cierta planta durante su reproducción, desarrollando una técnica para visualizarlos.
Fue recién en los años 1960s cuando se descubrieron los primeros elementos transponibles en bacterias, estudiándolos a nivel molecular. Más tarde, se lograron identificar en los genomas de otros organismos, como Drosophila y las levaduras. -
 Jodhua Lederberg y Norton Zinder.
Jodhua Lederberg y Norton Zinder.
La transducción descubierta por Lederberg y Zinder se llama transducción generalizada. Mediante ella se puede transferir cualquier marcador del genóforo del donador, con aproximadamente la misma frecuencia relativa (de ahí el calificativo de generalizada). -
 James Watson, Francis Crick y Rosalind Franklin.
James Watson, Francis Crick y Rosalind Franklin.
Rosalind Franklin empezó a experimentar con la difracción de rayos X para estudiar la molécula de ADN y al poco tiempo creó la icónica "Foto 51" junto a Raymond Gosling, un estudiante de doctorado que colaboraba con su departamento.
Así, gracias al trabajo de Franklin y a sus propias aportaciones, los dos científicos de la universidad de Cambridge construyeron el primer modelo correcto de la molécula de ADN, con una doble hélice. -
 F. Marcfarlane Burnett explicó la memoria inmunológica como la clonación de dos tipos de linfocitos. Un clon se usaba de inmediato contra la infección, mientras que el otro clon es más duradero, permaneciendo en el sistema inmune por mucho tiempo, lo que resulta en la inmunidad a ese antígeno.
F. Marcfarlane Burnett explicó la memoria inmunológica como la clonación de dos tipos de linfocitos. Un clon se usaba de inmediato contra la infección, mientras que el otro clon es más duradero, permaneciendo en el sistema inmune por mucho tiempo, lo que resulta en la inmunidad a ese antígeno. -
Arthur Pardee, Francois Jacob y Jacques Monod.
-
 Rodney Porter.
Rodney Porter.
A finales de la década de 1940 centró sus investigaciones en el estudio de la estructura y las funciones de los anticuerpos. ... Durante la década de 1950, Porter purificó, separó y analizó las moléculas de inmunoglobulina G (IgG) de los conejos, y descubrió la parte del anticuerpo que enlaza con los antígenos -
 Francois Jacob, David Perrin, Carmen Sánchez y Jaques Monod.
Francois Jacob, David Perrin, Carmen Sánchez y Jaques Monod.
El primer operón descrito fue el operón de la lactosa en Escherichia coli por F. Jacob, D. Perrin, C. Sánchez y J. Monod, publicado en la revista "Comptes rendus hebdomadaires des séances de l'Académie des sciences" en 1960.En parte gracias a estos trabajos sobre regulación génica, Jacob y Monod fueron galardonados con el Premio Nobel en Fisiología o Medicina en 1965 junto con André Lwoff. -
 Esta técnica fué desarrollada por Rosalyn Yalow y Solomon A. Berson en 1960 para determinar la concentración de insulina en el plasma sanguíneo.
Esta técnica fué desarrollada por Rosalyn Yalow y Solomon A. Berson en 1960 para determinar la concentración de insulina en el plasma sanguíneo. -
 En 1960, Sydney Brennen, Francois Jacob y Matthew Meselson demostraron la existencia del ARN mensajero, el intermediario encargado de llevar la información contenida en los genes hasta las factorías que producen proteínas en las células.
En 1960, Sydney Brennen, Francois Jacob y Matthew Meselson demostraron la existencia del ARN mensajero, el intermediario encargado de llevar la información contenida en los genes hasta las factorías que producen proteínas en las células. -
 Marshall Nirenberg, Har Gobind Khorana, y sus colegas, eran los primeros en determinar la clave genética y mostrar cómo las bases del ácido nucléico, con su alfabeto compuesto de A, U, G, y C, determinan la serie de los 20 diversos aminoácidos durante síntesis de la proteína.
Marshall Nirenberg, Har Gobind Khorana, y sus colegas, eran los primeros en determinar la clave genética y mostrar cómo las bases del ácido nucléico, con su alfabeto compuesto de A, U, G, y C, determinan la serie de los 20 diversos aminoácidos durante síntesis de la proteína. -
Thomas Brock.
-
 El descubrimiento de la transcriptasa inversa en 1970 por dos virólogos estadounidenses, David Baltimore y Howard Temin. Los retrovirus son virus RNA positivos de cadena sencilla con envoltura. Estos virus se conocen como retrovirus ya que replican por medio de intermediarios de DNA porque codifican una enzima conocida como transcriptasa inversa, que convierte el genoma RNA en una copia de DNA de doble cadena que, más tarde, se integra en el cromosoma del hospedador.
El descubrimiento de la transcriptasa inversa en 1970 por dos virólogos estadounidenses, David Baltimore y Howard Temin. Los retrovirus son virus RNA positivos de cadena sencilla con envoltura. Estos virus se conocen como retrovirus ya que replican por medio de intermediarios de DNA porque codifican una enzima conocida como transcriptasa inversa, que convierte el genoma RNA en una copia de DNA de doble cadena que, más tarde, se integra en el cromosoma del hospedador. -
 Thomas Brock y Hudson Freeze.
Thomas Brock y Hudson Freeze.
Es la fuente de la enzima resistente al calor Taq ADN polimerasa , una de las enzimas más importantes en la biología molecular debido a su uso en la reacción en cadena de la polimerasa (PCR), técnica de amplificación de ADN. -
Hamilton Smith
-
 El último trabajo, de Stanley Cohen, Annie Chang, Herbert Boyer y Robert Helling, permitió construir plásmidos bacterianos in vitro. Dando como resultado la capacidad de "cortar y pegar" ADN, una posibilidad que anticipaba la modificación genética de organismos vivos
El último trabajo, de Stanley Cohen, Annie Chang, Herbert Boyer y Robert Helling, permitió construir plásmidos bacterianos in vitro. Dando como resultado la capacidad de "cortar y pegar" ADN, una posibilidad que anticipaba la modificación genética de organismos vivos -
 En 1975 Georges Köhler y el investigador argentino César Milstein fusionaron por primera vez linfocitos con células de un mieloma y obtuvieron un hibridoma: una línea celular inmortal capaz de producir anticuerpos específicos (monoclonales).
En 1975 Georges Köhler y el investigador argentino César Milstein fusionaron por primera vez linfocitos con células de un mieloma y obtuvieron un hibridoma: una línea celular inmortal capaz de producir anticuerpos específicos (monoclonales). -
 Susumu Tonegawa. Gracias a sus trabajos se ha podido conocer cuántos genes de inmunoglobulinas tiene el ser humano, y cómo dan lugar a multitud de anticuerpos específicos.
Susumu Tonegawa. Gracias a sus trabajos se ha podido conocer cuántos genes de inmunoglobulinas tiene el ser humano, y cómo dan lugar a multitud de anticuerpos específicos. -
 Fred Sanger comenzó a usar la enzima ADN polimerasa para producir nuevas hebras de ADN a partir de plantillas de hebra única, introduciendo nucleótidos radiactivos en el nuevo ADN. Sanger y colega británico Alan R. Coulson desarrolló el “más y menos” método para la secuenciación rápida del ADN . Generó una serie de moléculas de ADN de diferentes longitudes que podrían separarse mediante electroforesis en gel de poliacrilamida .
Fred Sanger comenzó a usar la enzima ADN polimerasa para producir nuevas hebras de ADN a partir de plantillas de hebra única, introduciendo nucleótidos radiactivos en el nuevo ADN. Sanger y colega británico Alan R. Coulson desarrolló el “más y menos” método para la secuenciación rápida del ADN . Generó una serie de moléculas de ADN de diferentes longitudes que podrían separarse mediante electroforesis en gel de poliacrilamida . -
Carl Woese y George Fox.
-
 Los trabajos de Stanley Prusiner lo llevaron a un descubrimento sorprendente: el axente infeccioso causante de la ECJ carecía de ácidos nucleicos (la base de la transmision de la información genética): estaba constituido únicamente por proteína. Prusiner denominó a esta nueva entidad biológica “prión”. Los priones son agregados proteicos que se propagan al imponer su forma a una proteína de conformación normal.
Los trabajos de Stanley Prusiner lo llevaron a un descubrimento sorprendente: el axente infeccioso causante de la ECJ carecía de ácidos nucleicos (la base de la transmision de la información genética): estaba constituido únicamente por proteína. Prusiner denominó a esta nueva entidad biológica “prión”. Los priones son agregados proteicos que se propagan al imponer su forma a una proteína de conformación normal. -
 Luc Montagnier
Luc Montagnier
La identificación del virus de la inmunodeficiencia humana (VIH) como causa del síndrome de inmunodeficiencia adquirida (SIDA) es uno de los descubrimientos más espectaculares y trascendentes de la medicina moderna. No cabe duda que fue Luc Montagnier y su grupo en el Instituto Pasteur, en París, quienes aislaron por primera vez el virus que a la postre se demostraría como agente causal del SIDA. -
Luc Montagnier
-
 Kary Banks Mullis inventa en 1983 la reacción en cadena de la polimerasa o PCR.
Kary Banks Mullis inventa en 1983 la reacción en cadena de la polimerasa o PCR.
La PCR (reacción en cadena de la polimerasa) es la técnica de biología molecular que permite obtener una gran cantidad de copias de un fragmento de ADN. Gracias a este proceso de amplificación podemos, por ejemplo, identificar individuos en genética forense, detectar enfermedades infecciosas, diagnosticar trastornos hereditarios, o llevar a cabo diversos experimentos ligados a la investigación científica. -
 Norman Pace
Norman Pace -
-
 Hecho por Jed Fuhrman y Edward DeLong.
Hecho por Jed Fuhrman y Edward DeLong. -
 Craig Venter y Hamilton Smith. Varios genomas virales y organelas habían sido secuenciados antes de 1995 —por ej., el del bacteriófago Phi-X174 por Fred Sanger y colaboradores en 1977, el genoma de Vaccinia (virus vacuna), genomas de cloroplastos de Marchantia y el genoma del virus que causa viruela—, año en el que Venter y colaboradores publican el primer genoma bacteriano: Haemophilus influenzae.
Craig Venter y Hamilton Smith. Varios genomas virales y organelas habían sido secuenciados antes de 1995 —por ej., el del bacteriófago Phi-X174 por Fred Sanger y colaboradores en 1977, el genoma de Vaccinia (virus vacuna), genomas de cloroplastos de Marchantia y el genoma del virus que causa viruela—, año en el que Venter y colaboradores publican el primer genoma bacteriano: Haemophilus influenzae. -
 En los años 90 la combinación de avances tecnológicos y la adopción de procesos industriales incrementó el rendimiento y redujo los errores de secuenciación. Estos avances aceleraron la creación del proyecto del genoma humano (HGP) que estaba dirigido a producir mapas genéticos y finalmente completó la secuencia los cromosomas humanos en 2003.
En los años 90 la combinación de avances tecnológicos y la adopción de procesos industriales incrementó el rendimiento y redujo los errores de secuenciación. Estos avances aceleraron la creación del proyecto del genoma humano (HGP) que estaba dirigido a producir mapas genéticos y finalmente completó la secuencia los cromosomas humanos en 2003.
Plan projects on a visual timeline
Map milestones, phases, deadlines, and key events in one place so the sequence is easier to see and share. Timetoast is a timeline maker for work, school, research, and stories.
